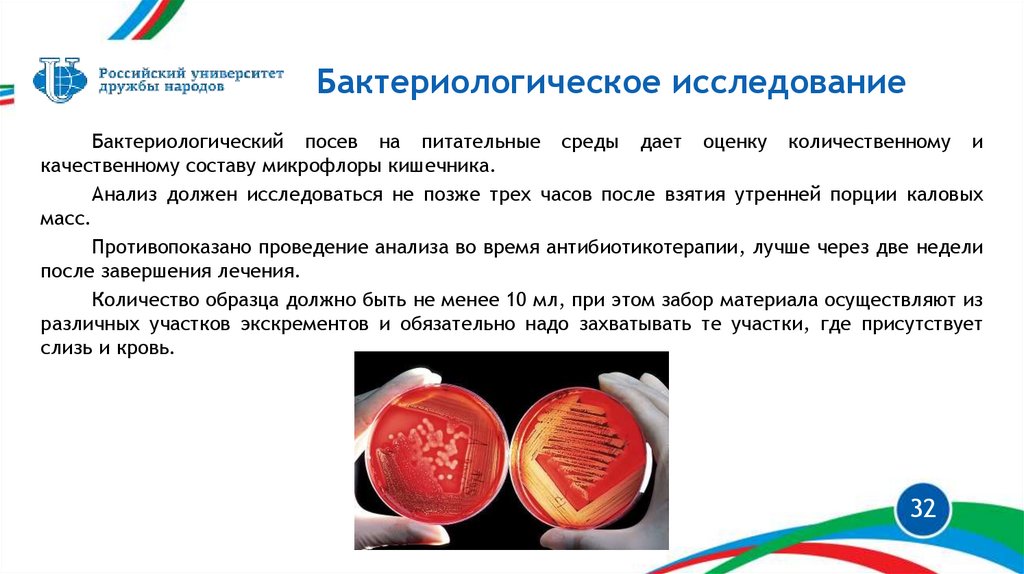

Similar presentations:
занятие 11_гл_17 и 18
1.
АККРЕДИТАЦИОННО-СИМУЛЯЦИОННЫЙ ЦЕНТРКлинико-лабораторные методы
исследования в сестринской практике
2.
Этапы лабораторных исследованийЛабораторные исследования являются дополнительным объективным методом
обследования пациента.
В условиях стационара этапы лабораторных исследований начинаются, когда
медицинская сестра приемного отделения, либо палатная медицинская сестра
выписывает из листа врачебных рекомендаций больного в специальный журнал
регистрации все виды лабораторных исследований.
Этапы лабораторного анализа:
преаналитический
назначение
теста
врачом,
взятие
материала,
транспортировка образца в лабораторию;
аналитический - исследование образца в лаборатории;
постаналитический - интерпретация результатов, диагноз и лечение пациента
2
3.
Биологический материалБиологическим материалом для исследования являются:
кровь и ее компоненты;
выделения (моча, кал, мокрота);
содержимое желудка, 12-перстной кишки;
желчь;
спинномозговая жидкость;
экссудаты, транссудаты;
пунктаты;
клетки тканей;
налеты слизистой оболочки зева и носа, прямой кишки.
3
4.
Типы основных лабораторныхисследований
Основные типы лабораторных исследований:
общеклинические тесты — самые распространенные. К ним относятся: общий анализ крови, общий
анализ мочи, исследование мочи по методу Зимницкого, Нечипоренко, исследование мокроты и др.;
биохимические — для определения содержания веществ, которые образуются в процессе
биохимических реакций. Виды анализов: определение общего белка, мочевины, креатинина, глюкозы,
трансаминаз (АСТ, АЛТ), общего холестерина и др.;
иммунологические — диагностические методы, основанные на специфическом взаимодействии
антигенов и антител (иммуноферментативный анализ на ВИЧ-инфекцию и другие анализы);
серологические — исследования взаимодействия антигенов и антител в крови пациентов для
определения конкретных вирусов и бактерий, вызывающих инфекционные заболевания. К этому способу
относится и определение группы крови и резус-фактора;
микробиологические — методы обнаружения возбудителей инфекционно-воспалительных процессов,
определения их чувствительности к лекарственным препаратам и оценка эффективности лечения.
Например, исследование мочи на микрофлору и чувствительность к антибиотикам;
цитологические — это оценка характеристик морфологической структуры клеточных элементов с целью
установления диагноза доброкачественной или злокачественной опухоли и неопухолевых поражений.
4
5.
КровьКровь – жидкая ткань, осуществляющая в
организме транспорт химических веществ и
кислорода,
благодаря
которому
происходит
интеграция биохимических процессов, протекающих
в
различных
клетках
и
межклеточных
пространствах, в единую систему.
Кровь состоит из жидкой части – плазмы и
взвешенных
в
ней
клеточных
(форменных)
элементов.
К форменным элементам крови относятся
эритроциты,
лейкоциты,
представленные
гранулоцитами
(нейтрофильные, эозинофильные
и базофильные гранулоциты) и агранулоцитами
(лимфоциты и моноциты), а также тромбоциты
– кровяные пластинки.
5
6.
Виды анализов кровиАнализы крови – наиболее точный способ диагностики заболеваний.
Под влиянием внешних и внутренних воздействий кровь способна изменять
свой состав, что помогает увидеть объективную картину состояния здоровья
пациента, правильно поставить диагноз и составить наиболее корректную схему
лечения.
Клинический анализ крови.
Биохимический анализ крови.
Другие виды анализов:
цитогенетические
иммунологические
гормональные
серологические
6
7.
Клинический анализ крови (1)Клинический (общий) анализ крови - исследование, которое входит в состав
диагностических мероприятий при любых заболеваниях.
Забор необходимого количества биоматериала может осуществляться из
пальца или вены.
Перед проведением процедуры за 8 часов необходимо полностью исключить
приём пищи и напитков. Употреблять можно только питьевую воду без газа.
Клинический анализ крови определяет:
Состояние иммунной системы организма
Уровень гемоглобина
Наличие и остроту воспалительного процесса
Наличие аллергических или паразитарных заболеваний
Нарушения процесса свёртываемости крови
7
8.
Клинический анализ крови (2)8
9.
Биохимический анализ крови (1)Биохимический анализ крови даёт наиболее полное представление о
функционировании всех органов и систем человека.
Биоматериал для исследования берётся из вены в количестве не более 5
мл и распределяется по нескольким пробиркам.
Планово забор крови производится исключительно по утрам.
Для ряда показателей, существуют определенные условия их
определения.
К примеру, глюкоза.
При сдаче крови на глюкозу (в дополнение к основным требованиям
подготовки к анализам) нельзя чистить зубы и жевать резинку, пить
чай/кофе (даже несладкий). Также оказывают влияние мочегонные средства
и другие лекарства.
9
10.
Биохимический анализ крови (2)10
11.
Вакуумный забор крови (1)Вакуумный забор крови является оптимальным для взятия образцов на
исследование.
Вакуумные системы забора крови – гарантия безопасности каждого
пациента и медицинского работника.
Все составляющие системы предназначены только для одноразового
использования.
Принцип действия системы: под действием вакуума кровь втягивается в
пробирку с реагентом и сразу с ним смешивается.
Определенное количество реагента и нужный для исследования объем
крови обеспечивают точное соотношение компонентов для исследования.
11
12.
Вакуумный забор крови (2)Стандартная система для вакуумного забора крови состоит из трех
компонентов:
обоюдоострая игла для венепункции;
держатель (переходник) для фиксации иглы;
вакуумная пробирка с реагентом.
12
13.
Вакуумный забор крови (3)Пробирки для вакуумного забора крови изготавливаются из поливинилхлорида. Имеют
безопасную крышку с резиновой пробкой. Крышки различаются по цветовой гамме в силу
применения для того или иного исследования.
Пробирка
Цвет
крышки
Реагент
Объект исследования
Назначение
Красный
Без наполнителя
Сыворотка крови
Клиническая химия, иммунология, серология,
токсикология, микробиология, электрофорез
белков
Зеленый
Гепарин, литийгепарин
Плазма крови
Биохимия, клиническая химия
Голубой
Цитрат натрия
Цельная венозная кровь
Гемостаз
Черный
Цитрат натрия
Цельная кровь
Определение СОЭ в ускоренном режиме (30
минут) с результатом, эквивалентным
стандартному исследованию за 1 час
13
14.
КоагулограммаКоагулограмма – комплексное гематологическое исследование, направленное на
оценку состояния системы гемостаза (свертывание крови), или показателей
свертывания крови. В систему гемостаза входят клетки крови (тромбоциты) и
специфические вещества (факторы свертывания), растворенные в плазме крови и
содержащиеся в тромбоцитах.
Коагулограмма назначается перед проведением хирургического вмешательства,
для диагностики и лечения тромбозов, при заболеваниях органов кроветворения,
заболеваниях печени и сердечно-сосудистой системы и др.
14
15.
Гормональные исследованияГормональные
исследования
—
это
комплекс
лабораторно-диагностических
мероприятий, направленных на изучение концентрации и наличия в крови ряда гормонов.
Гормоны — это биологически активные вещества, которые вырабатываются органами
эндокринной системы.
Как правило, гормональные исследования рекомендовано проводить при подозрениях
на сбои в работе органов внутренней секреции. Например: заболевания щитовидной
железы, нарушения функции яичников и почек, избыточный рост волос на теле, остеопороз
и др.
15
16.
Иммунологический анализ крови иаллергологические исследования
Иммунологический анализ крови – комплекс методов лабораторной диагностики,
предназначенный для оценки общего состояния иммунного статуса организма и выявления
нарушенных звеньев в иммунной системе.
Данный метод исследования рекомендуется применять в случаях, когда пациента беспокоят:
Частые инфекционные заболевания.
Снижение защитных функций организма.
Осложнения после операций.
Аллергические реакции.
Хроническая усталость.
Резкое снижение веса.
Аллергологическое исследование - определяется
содержание иммуноглобулина Е в сыворотке крови.
16
17.
ПЦРПолимеразная цепная реакция (ПЦР) – это один самых точных методов при
проведении анализов, позволяющий диагностировать очень широкий спектр инфекций, в
том числе и передающихся половым путем. Суть анализа заключается в идентификации
ДНК или РНК инфекционных возбудителей в крови человека.
Чаще всего данное исследование назначается при серьёзных заболеваниях:
Герпетические инфекции
Вирусные гепатиты (А, B, С,D,TT)
Подозрение на цитомегаловирус
Инфекционный мононуклеоз
Токсоплазмоз
Опоясывающий лишай
Краснуха
Коронавирусная инфекция
17
18.
Группы кровиСуществует более 30 групп крови.
Самой распространенной системой является система АВ0.
Система крови АВO представлена агглютиногенами A и B, являющиеся
гликопротеинами и расположенными на поверхности эритроцитов, и агглютининами α
и β, которые относятся к классу IgM и циркулируют в плазме крови.
В этой системе выделяют 4 группы крови: I (0), II (A), III (B) и IV (AB).
Группа
крови
Эритроциты
Плазма/сыворотка
Агглютиногены
Агглютинины
I (0)
0
α, β
II (A)
А
β
III (B)
В
α
IV (AB)
АВ
0
18
19.
Резус-факторРезус-фактор (Rh) - это белок, который расположен на поверхности эритроцитов.
Кровь, содержащая данный белок, является резус-положительной. При отсутствии
отсутствуют и их кровь является резус-отрицательной – Rh(-).
19
20.
Определение группы крови ирезус-фактора
20
21.
Виды анализа мочиОбщий анализ мочи
Исследование суточной мочи на глюкозу
Взятие мочи на глюкозурический профиль
Анализ мочи по Нечипоренко
Анализ мочи по Зимницкому
Посев на микрофлору
Анализ мочи на чувствительность к антибиотикам
21
22.
Общий анализ мочиОбщий клинический анализ мочи — это физико-химическое исследование мочи (ее количества,
цвета, прозрачности, удельного веса, кислотности, запаха) и микроскопическое изучение ее
осадка.
Исследуемые параметры :
прозрачность мочи;
цвет мочи;
уровень кислотности и удельный вес.
обязательно оценивается наличие таких показателей, как:
белок в моче;
сахар (глюкоза);
кетоновые тела;
билирубин;
эритроциты, лейкоциты;
клетки эпителиальной ткани и цилиндры;
гемоглобин.
22
23.
Исследование суточной мочи наглюкозу
До 7 часов утра необходимо опорожнить мочевой
пузырь (эту порцию мочи вылить), а затем в течение суток
собирать всю мочу в банку. Последнюю порцию собирать
точно в то же время, когда накануне был начат сбор мочи.
Сбор мочи осуществляется при обычном водно-пищевом
и двигательном режиме (нельзя принимать диуретики!).
Собранная моча хранится в прохладном месте.
Количество
суточной
мочи
измеряют,
тщательно
перемешивают и отливают приблизительно 50 мл в
контейнер для сбора мочи.
23
24.
Анализ мочи по Нечипоренко (1)Оценка количественного содержания в 1 мл мочи эритроцитов, лейкоцитов и цилиндров.
Подготовка пациента.
За 3 суток до исследования:
не принимать растительную пищу, т.к. она может повлиять на цвет мочи (свекла, морковь и т.д.);
не принимать диуретики и продукты с мочегонным действием.
за сутки до теста:
не принимать энергетические и алкогольные напитки;
исключить физические нагрузки и эмоциональный стресс.
дополнительная информация:
проводят анализ мочи не ранее, чем на 7-е сутки после цистоскопии;
во время менструаций не рекомендуется сдавать анализ.
24
25.
Анализ мочи по Нечипоренко (2)Правила сбора мочи:
1. Чтобы снизить риск попадания бактерий потовых и сальных желез в биоматериал (мочу),
необходимо перед сбором мочи тщательно провести гигиенический туалет половых органов.
2. Сразу после пробуждения берется средняя порция утренней мочи для анализа:
в унитаз сливается первые 15-20 мл мочи, т.к. в ней содержится большое количество
органических примесей;
собирается средняя порция объемом не меньше 30 мл в стерильный контейнер;
последнюю порцию мочи также сливают в унитаз.
3. К контейнеру прикрепляется ФИО пациента или направление,
полученное от врача.
25
26.
Анализ мочи по Зимницкому (1)Подготовка к анализу.
Заблаговременно подготовить 8 чистых сухих банок для сбора мочи. Все емкости подписать, указать ФИО
пациента, отделение, дату и время сбора мочи.
1-я банка – с 6 до 9 часов,
2-я – с 9 до 12 часов,
3-я – с 12 до 15 часов,
4-я – с 15 до 18 часов,
5-я – с 18 до 21 часа,
6-я – с 21 до 24 часов,
7-я – с 24 до 3 часов,
8-я – с 3 до 6 часов.
26
27.
Посев на микрофлору (1)Для определения количественного и качественного состава обнаруженных бактерий,
микробов и другой микрофлоры используют посев мочи на микрофлору. А также степень
инфицирования органов мочеполовой системы и уровень чувствительности патогенных
организмов к основной группе антибиотиков.
Подготовка пациента к сбору мочи на микрофлору:
Перед сдачей биологического материала за 14 дней до исследования необходимо
отказаться от приема антибактериальных препаратов после предварительной
консультации с лечащим врачом, для обеспечения правдивых результатов.
За сутки до сбора мочи необходимо отказаться от физических нагрузок, так как они
влекут увеличение количества белка в организме.
Ограничить употребление красящих продуктов питания за сутки до сбора урины.
27
28.
Анализ мочи на чувствительность кантибиотикам (1)
Способы определения:
1. Методом дисков – на питательную среду высевается
моча и сверху на области с мочой выкладываются диски,
пропитанные
раствором
антибиотиков.
Затем
все
помещается в термостат и с течением времени на
питательной среде образуются вокруг дисков зоны, где не
будет роста возбудителя. Диаметр свободной от бактерий
зоны измеряется.
28
29.
Анализ мочи на чувствительность кантибиотикам (2)
Методом разведения - основан на принципе уменьшения концентрации
антибиотика путем постепенного разведения. Начинают с максимально высокой
дозы, далее концентрация препарата снижается. В одной из пробирок рост колонии
прекращается. По ней определяют дозу препарата.
29
30.
КалКал (лат. faeces — «фекалии», «экскременты») — совокупность отходов
жизнедеятельности и непереваренных остатков пищи, выделяемых во внешнюю среду из
дистального отдела кишечника в процессе акта дефекации.
Кал состоит из воды (70-80 %) и сухого остаток.
Сухой остаток состоит из 50% живых бактерий и 50% остатков переваренной пищи.
Выделяют следующие группы нарушений состава каловых масс:
изменение количества компонентов, содержащихся в норме;
нерасщепленные и/или неусвоенные остатки пищи;
биологические элементы и вещества, выделяемые из организма в просвет кишечника;
различные вещества, которые образуются в просвете кишечника из продуктов обмена
веществ, тканей и клеток тела;
микроорганизмы;
инородные включения биологического и другого происхождения.
30
31.
Виды анализов калаКопрограмма.
Анализ химических и физических характеристик кала. Развернутый анализ содержит больше 20
показателей, полученных в результате химического, макро- и микроскопического исследования.
Тест на скрытую кровь.
Назначается при подозрении на кровотечение в любом из отделов пищеварительного тракта.
Анализ на дисбактериоз.
Выявление 15 основных видов патогенных бактерий, грибов, микроорганизмов. Назначается при
различных нарушениях в работе ЖКТ.
Анализ для определения наличия паразитов.
Может быть назначен как общий, так и избирательный.
31
32.
Бактериологическое исследованиеБактериологический посев на питательные среды дает оценку количественному и
качественному составу микрофлоры кишечника.
Анализ должен исследоваться не позже трех часов после взятия утренней порции каловых
масс.
Противопоказано проведение анализа во время антибиотикотерапии, лучше через две недели
после завершения лечения.
Количество образца должно быть не менее 10 мл, при этом забор материала осуществляют из
различных участков экскрементов и обязательно надо захватывать те участки, где присутствует
слизь и кровь.
32
33.
БиопсияБиопсия – это метод исследования,
при
котором
проводится
прижизненный забор клеток или
тканей
из
организма
с
диагностической целью.
Пункционная биопсия щитовидной железы
33
34.
АККРЕДИТАЦИОННО-СИМУЛЯЦИОННЫЙ ЦЕНТРИнструментальные методы
исследования
35.
Инструментальные методы диагностикиделятся
Инвазивные
Неинвазивные
К инвазивным (с введением датчика, либо диагностических веществ)
методам относятся :
Достоверность и
Ангиография;
информативность результатов
инструментальных методов
Гастрофиброскопия;
исследования в немалой степени
Пневмоэнцефалография;
зависят от качества подготовки
Радиационные методы и др.
К неинвазивным методам относятся (без введения датчика):
Рентгеновские;
Электрические;
Ультразвуковые методы;
пациентов к проведению этих
исследований.
35
36.
Все исследования проводят в соответствии сприказом Министерства здравоохранения РФ от 9 июня
2020г. № 560н «Об утверждении Правил проведения
рентгенологических исследований».
К наиболее широко распространенным
методам исследования относят:
- Рентгенологические методы;
- Эндоскопические методы;
- Ультразвуковые методы;
- Радиоизотопные методы.
36
37.
Рентгенологические методы обследованияРентгенологический метод - способ изучения строения и функции различных
органов и систем, основанный на качественном и количественном анализе пучка
рентгеновского излучения, прошедшего через тело человека. При прохождении
через тело человека пучок рентгеновского излучения ослабевает.
37
38.
Обзорные снимки - это рентгенограммы, на которых получаетотображение целиком вся снимаемая область: голова, грудь, брюшная
полость, сегмент конечности и т. д. Обзорные снимки делаются на
пленках 30х40 см или 24х30 см в зависимости от величины
снимаемого объекта.
38
39.
Прицельныеснимки
изображение
ограниченного участка исследуемого органа, где
предполагается патологический процесс;
Текст набирается шрифтом Trebuchet от 16 кегля
39
40.
Суперэкспонированными - снимки показанытакже для разграничения воспалительного
уплотнения от ателектатически спавшейся
легочной ткани, при инфильтративных корневых
изменениях, бронхоаденитах, и при исследовании
органов средостения с целью выявления
увеличенных лимфатических узлов, уточнения
состояния трахеи, крупных бронхов и парамедиастинальных сращений.
40
41.
Уменьшенные снимкиУменьшенные снимки - это флюорография.
Флюорография - способ массового поточного
рентгенологического обследования, состоящий в
фотографировании рентгеновского изображения
с
просвечивающего
экрана
на
пленку
фотоаппарата. В соответствии с Федеральным
законом от 18 июня 2001 г. N 77-ФЗ "О
предупреждении распространения туберкулеза в
Российской Федерации" (с изменениями и
дополнениями на 3 августа 2018 года)
флюорографию
проводят
с
целью
профилактического
исследования
органов
грудной полости 1 раз в год всем людям с 15летнего возраста. Однако в группах повышенного
риска флюорография проводится чаще (2 раза в
год).
41
42.
Подготовка к проведениюрентгеновских снимков
Практически никакой подготовки к прохождению процедуры не требуется. До
обследования нужно раздеться до пояса, снять все украшения, убрать длинные
волосы наверх.
42
43.
Томография - получение снимков отдельных слоевизучаемой области: легких, почек, мозга, костей.
Компьютерную томографию используют для получения
послойных снимков исследуемой ткани.
43
44.
Компьютерная томография (КТ) метод сканирования исследуемого объектаR-излучением
с
последующим
компьютерным
отображением
без
применения
контрастных
веществ.
Диагностика позволяет оценить мелкие
анатомические структуры внутренних
органов. При КТ исследуются голова и
шея, а также грудная и брюшная полости.
Наибольшее значение исследование имеет
в травматологии, нейрохирургии и при
исследовании сосудов. В онкологии
компьютерная томография определяет
степень распространённости опухолевого
процесса и позволяет спланировать
лучевую терапию.
44
45.
Магниторезонансная томография (МРТ) — этодиагностический метод получения послойного
изображения тканей органов человеческого
организма при помощи феномена магнитоядерного
резонанса. Принцип исследования основан на
взаимодействии радиоволн и магнитного поля
вместо использования небезопасного
рентгеновского излучения. Датчики прибора
расположены по кругу, в результате получается не
обычная фотография, как рентгеновский снимок, а
объемное изображение обследуемого органа в
нескольких плоскостях. МРТ позволяет
визуализировать с высоким качеством внутренние
органы, головной и спинной мозг, кости и суставы.
Современные методики МРТ делают возможным
неинвазивное исследование функций органов измерение скорости кровотока, тока
спинномозговой жидкости, определение уровня
диффузии в тканях, позволяют наблюдать
активацию коры головного мозга при
функционировании органов, за которые отвечает
данный участок коры (функциональная МРТ).
45
46.
Подготовка к проведению МРТ брюшной полости:в течение суток необходимо отказаться от продуктов питания,
повышающих газообразование (газированные напитки, кисломолочные
продукты, черный хлеб, фрукты, овощи);
при проведении МРТ селезенки, печени, поджелудочной железы
иногда рекомендуют безуглеводную диету за 2-3 дня до процедуры;
в день проведения диагностики желательно употреблять легкую
пищу, отказаться от кофе и чая;
после последнего приема пищи должно пройти не менее 6-8
часов;
следует воздержаться от питья 4-6 часов перед обследованием;
при повышенном газообразовании рекомендуется принять
таблетку Эспумизана или активированного угля;
за 30-40 минут до процедуры желательно выпить таблетку НоШпы или другого спазмолитика;
нужно иметь при себе всю необходимую медицинскую
документацию, касающуюся исследуемого органа (данные УЗИ, КТ,
рентгена, послеоперационные выписки).
Чтобы сделать вам МРТ брюшной полости, врачу понадобится
от 30 до 60 минут.
Часто
для
улучшения
информативности
диагностики
используется МРТ брюшной полости с контрастом. Оно подразумевает
введение в кровь специального контрастирующего препарата, который
накапливается в исследуемом органе и позволяет подсветить
46
поврежденные участки на снимках.
47.
Виды рентгенографииМаммография
НОРМА
ПАТОЛОГИЯ
47
48.
Рентгенография брюшной полости48
49.
Подготовка пациента к обзорнойрентгенографии брюшной полости:
Перед рентгенологическими исследованиями органов брюшной полости необходимо убрать
«помехи» - скопление газов и каловых масс, затрудняющие проведение исследования. С этой целью
используются:
-бесшлаковая диета в течении 3-х дней до предстоящего исследования:
Исключаются!!!: продукты, содержащие грубую растительную клетчатку и способствующие
возбуждению деятельности кишечника: овощи, фрукты, ягоды, кондитерские изделия, пряности,
молоко, черный хлеб, газированные напитки.
Разрешаются: пшеничные сухари, слизистые супы, мясо, курица, нежирная рыба, каши на воде,
кисломолочные продукты., творог 0.6% (маложирный), чай, кисель и желе из черники, черной
смородины, вишни.
прием ферментных препаратов (фестал, мезим) и активированного угля в течении 3-х дней до
исследования;
легкий ужин не позднее 19:00 накануне исследования: постановка очистительных клизм и
газоотводной трубки накануне и в день исследования, (но не позднее, чем за 2 часа до исследования,
49
так как изменяют цвет и рельеф слизистой оболочки кишечника!!!);
Перед рентгенологическим исследованием некоторых органов проводится их контрастирование.
50.
Подготовка пациента к ирригоскопии (исследованиетолстой кишки):
- соблюдение бесшлаковой диеты в течение 3 дней до исследования;
- по назначению врача - прием ферментов и активированного угля в течение 3 дней до
исследования;
- днем накануне исследования прием слабительных - перорально или ректально;
- увеличение количества жидкости со второй половины дня накануне исследования;
- ужин исключается;
- постановка 2-3 очистительных клизм вечером и 2-3 утром в день исследования с
интервалом в 1 час, последняя - не позднее 2 часов до исследования (или прием
слабительных).
- утром в день исследования пациент получает белковый завтрак (непосредственно
перед ирригоскопией).
50
51.
Рентгенография костей, суставов и позвоночника51
52.
Рентгенография костей, суставов и позвоночникаТекст набирается шрифтом Trebuchet от 16 кегля
52
53.
Рентгенография костей, суставов и позвоночника53
54.
Рентгенография носовых синусов54
55.
Урография55
56.
Подготовка пациента к бронхографии:Подготовка пациента к бронхографии:
проведение пероральной пробы на чувствительность к контрастному препарату перед исследованием;
утром в день исследования исключен прием пищи;
Подготовка пациента к пероральной холецистографии:
соблюдение бесшлаковой диеты в течение 3 дней до исследования;
по назначению врача - прием ферментов и активированного угля в течение 3 дней до исследования;
накануне вечером - легкий ужин не позднее 19.00;
прием контрастного препарата вечером (20.00) внутрь течение 1 часа через равные промежутки времени, запивать сладким чаем.
Максимальная концентрация препарата в желчном пузыре - через 15-17 часов после его приема.
Внимание!!!Исключен последующий прием пищи и лекарств;
постановка очистительных клизм вечером накануне и утром за 2 часа до исследования;
желателен сон на правом боку;
прийти на исследование утром в состоянии натощак с полотенцем;
Подготовка пациента к внутривенной холецистографии:
соблюдение бесшлаковой диеты в течение 3 дней до исследования;
проведение пробы за 1-2 дня до исследования на чувствительность к контрастному препарату;
по назначению врача - прием ферментов и активированного угля в течение 3 дней до исследования;
постановка очистительных клизм вечером и утром в день исследования;
прийти на исследование утром в состоянии натощак.
56
57.
Рентгенологический метод исследованиябронхов
57
58.
Внутривенная холецистографии58
59.
ЭРХПГЧЧПХГ
59
60.
Эндоскопическое исследованиеЭндоскопия - метод визуального исследования полостей и каналов тела при помощи
специальных оптических приборов (эндоскопов), снабженных волоконной оптикой.
Преимущества метода эндоскопии неоспоримы — это лечебно-диагностическое исследование:
позволяет определить патологические изменения органа;
позволяет с большой точностью визуально определить локализацию, характер и степень изменений в
слизистой оболочке этих органов;
дает возможность с помощью прицельной биопсии органов получить кусочек пораженной ткани для
гистологического исследования;
используется для введения лекарственного препарата, процедур прижигания, обкалывания;
позволяет удалять инородные тела, полипы;
применяется для диагностического контроля и объективной оценки динамики эффективности лечения.
Подготовку пациента, как и при других видах исследования, начинают с информации о цели и ходе
предстоящей процедуры.
60
61.
БронхоскопияПодготовка пациента к бронхоскопии:
утром, в состоянии натошак;
прием седативных препаратов;
процедуру осуществляют под местной анестезией.
61
62.
Бронхоскопия62
63.
Эндоскопическое исследованиежелудка и двенадцатиперстной кишки
ЭГДС(ФГДС)
Подготовка пациента к ФГДС:
накануне вечером — легкий ужин не
позднее 19.00;
прийти утром в состоянии натощак со
своим полотенцем (не пить, не курить, не
чистить зубы);
при наличии зубных протезов снять их
перед исследованием;
соблюдение
диеты
с
исключением
продуктов, вызывающих метеоризм, постановка
очистительных клизм вечером и утром в день
исследования
по показаниям.
63
64.
Раздел, содержащий только текст.Шрифт Trebuchet до 32 кегля
Текст набирается шрифтом Trebuchet от 16 кегля
64
65.
Эндоскопия толстой кишкиВыделяют:
1. Ректороманоскопия
2. Колоноскопия
Подготовка пациента к ректороманоскопии:
постановка очистительных клизм накануне вечером и
утром в день исследования, последняя - не позднее 2 часов до
исследования. Сама процедура клизмы изменяет рельеф
слизистой оболочки кишечника;
проводится исследование утром в состоянии натощак;
опорожнение мочевого пузыря перед исследованием.
Подготовка пациента к колоноскопии:
- соблюдение бесшлаковой диеты в течение 3 дней до
исследования;
- по назначению врача - прием ферментов и активированного
угля в течение 3 дней до исследования;
- днем накануне исследования прием слабительных — внутрь
или ректально;
- увеличение количества жидкости со второй половины дня
накануне исследования;
- накануне вечером - легкий ужин не позднее 19.00.
- постановка 2-3 очистительных клизм вечером и 2 - 3 утром
вдень исследования, последняя - не позднее 2 часов до
65
исследования;
- прийти на исследование утром в состоянии натощак.
66.
6667.
Эндоскопическое исследование мочевогопузыря
Цистоскопия
67
68.
Эндоскопическое исследование органовбрюшной полости
1. Эндоскопическая ретроградная
панкреатохолангиография – ЭРХПГ
2. Диагностическая лапароскопия
68
69.
Ультразвуковое исследование69
70.
Электрокардиограмма70
71.
Раздел, содержащий только текст.Шрифт Trebuchet до 32 кегля
Текст набирается шрифтом Trebuchet от 16 кегля
71
72.
Холтеровское мониторированиеХолтеровское мониторирование
(ХМ) – это суточная непрерывная
регистрация ЭКГ на носитель
памяти. В последующем данные
отправляются
в
специальную
программу
для
расшифровки
результата.
72
73.
Эхокардиография (УЗИ сердца) – метод исследованиясердца, основанный на ультразвуковом сканировании грудной
полости, который даёт возможность получения наглядного
изображения сердца и сосудов. Эхо-КГ позволяет оценить общие
размеры как самого сердца, так и отдельных его структур
(желудочки, перегородки), толщину миокарда желудочков,
предсердий, а также определяет массу сердца, фракцию выброса и
другие параметры.
73
74.
БЛАГОДАРИМ ЗА ВНИМАНИЕ!74

medicine
medicine








